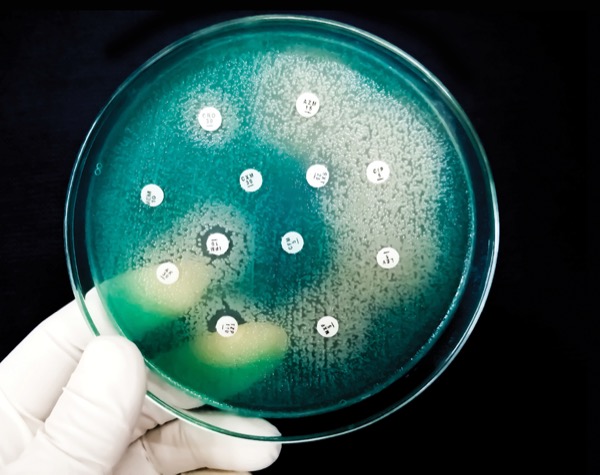

A new study has found two antibiotic combinations produced good results against Pseudomonas aeruginosa: ceftolozane-tazobactam (C/T; Zerbaxa, Merck) and ceftazidime-avibactam (CAZ/AVI; Avycaz, AbbVie).
The Problem of P. aeruginosa
P. aeruginosa is a cause of widespread infections in hospitals, accounting for approximately 7% of all hospital-acquired infections (Microorganisms 2025;13[4]:913) and causing some 2,700 estimated deaths in the United States, according to the CDC.
The epidemiology of antimicrobial-resistant, or difficult-to-treat (DTR), P. aeruginosa “is actually not well documented,” but it’s more common outside the United States. P. aeruginosa more often affects patients in ICUs, those who are immunocompromised or who have frequent exposures to the healthcare system, said Dariusz Hareza, MD, MHS, an assistant professor of medicine at Northwestern University Feinberg School of Medicine, in Chicago.
The organism is “known for its impressive ability to accumulate resistance mechanisms,” Dr. Hareza said, including expelling antibiotics through efflux pumps or decreasing expression of porins that allow antibiotics to enter the organism. During the last decade, several beta-lactam agents with activity against DTR P. aeruginosa isolates were approved by the FDA, but studies comparing these agents have been lacking, he and colleagues wrote in a recent study (Antimicrob Agents Chemother 2024;68[10]:e0090724) of C/T and CAZ/AVI.
Similar Efficacy With New Drugs
Even with good treatment, the prognosis for these patients can be poor. The prospective observational study, of 186 patients infected with DTR P. aeruginosa and treated with either of the two antibiotics between January 2018 and December 2023 at three hospitals in the Johns Hopkins Health System in the Baltimore area, found that nearly 1 in 5 hospitalized patients treated with either medication died within 30 days, “underscoring the alarming implications of drug-resistant P. aeruginosa infections,” they wrote. Mortality rates were similar among those treated with C/T and CAZ/AVI (21% vs. 17%; adjusted odds ratio [aOR], 1.01; 95% CI, 0.90-1.14).
Subsequent emergence of resistance was higher, but not statistically significant, in the C/T group (38% vs. 25%; aOR, 1.89; 95% CI, 0.98-4.88). While both agents appeared to be equally effective treatment options for DTR P. aeruginosa, the researchers noted, the findings suggest that if a patient has a subsequent DTR P. aeruginosa infection, “ceftazidime-avibactam may be more likely to retain activity if it was used to treat the index infection.”
C/T was administered at 3 g every eight hours in 73% of patients, with the remaining percentage receiving 1.5 g every eight hours for those with normal renal function. CAZ/AVI was administered at 2.5 g every eight hours over two hours for patients with normal renal function.
Seventy patients receiving either ceftolozane-tazobactam (53%) or ceftazidime-avibactam (47%) had a repeat P. aeruginosa culture within 90 days of the index culture collection date. Of these, 42 met the criteria for infection, including 20 patients in the C/T arm and 22 in the CAZ/AVI arm (P=0.33).
Prolonged treatment durations and use of continuous renal replacement therapy (CRRT) were associated with increased emergence of resistance (both P=0.04). While dosing guidelines for these agents among patients requiring CRRT are not available, findings from previous clinical experiences suggest the priority should be to optimize drug exposures with “robust dosages of” the agents versus dose reduction, the authors noted. Approximately 60% of those receiving CRRT did not receive the full dosing, potentially putting them at risk for resistance.
Limiting duration of the agents is important, Dr. Hareza said: “Just because something’s resistant does not mean you need to extend therapy. If it’s a pneumonia, it’s a pneumonia course. If it’s a UTI [urinary tract infection], it’s a UTI course.”
A Potential Growing Clinical Challenge
Most DTR P. aeruginosa in the United States are susceptible to two additional beta-lactam antibiotics, cefiderocol (Fetroja, Shionogi) and imipenem-cilastatin-relebactam (Recarbrio, Merck), according to a CDC spokesperson who did not wish to be identified. However, “susceptibilities will vary depending on which resistance mechanisms are common in a region. For DTR P. aeruginosa harboring carbapenemases, especially metallo-beta-lactamases, options are limited. While these types of DTR P. aeruginosa are currently relatively uncommon in the United States, outbreaks with these extremely resistant strains have been reported in U.S. healthcare settings.”
Resistant gram-negative bacterial infections in hospitalized patients increased during the COVID-19 pandemic and have remained elevated over pre-pandemic levels, said the spokesperson: “This, combined with the limited treatment options, means that DTR Pseudomonas infections are an ongoing, potentially growing clinical challenge.”
In the future, additional alternative therapies could become more mainstream. For example, phages that target P. aeruginosa isolated from sewage have been demonstrated in laboratory studies to penetrate the organism’s biofilm and disrupt its structure (Nat Commun 2024;15[1]:8572). Phages have been employed in isolated case studies as well. For now, clinicians would have to look through the populations of phages that laboratories have available to see whether one would benefit their patients, and get it approved for treatment from payors—a process lengthy enough that patients may not have enough time to wait, Dr. Hareza noted.
Another potential option is the use of CRISPR-Cas9 gene editing to cut genetic material from a bacterium. “There’s a lot of safety concerns about this, but the potential is enormous because this can be an extremely accurate way of just taking out the gene that you don’t want the Pseudomonas to have,” he said. “It’s very much in preliminary stages.”
Dr. Hareza and the CDC spokesperson reported no relevant financial disclosures.
This article is from the August 2025 print issue.